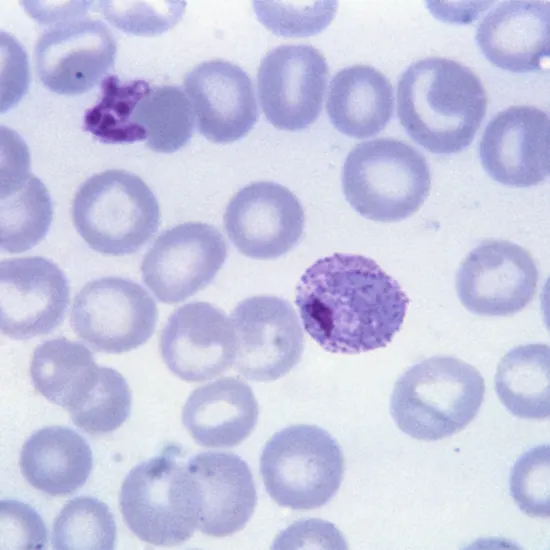

Book Antigen For Plasmodium Vivax Appointment Online Near me at the best price in Delhi/NCR from Ganesh Diagnostic. NABL & NABH Accredited Diagnostic centre and Pathology lab in Delhi offering a wide range of Radiology & Pathology tests. Get Free Ambulance & Free Home Sample collection. 24X7 Hour Open. Call Now at 011-47-444-444 to Book your Antigen For Plasmodium Vivax at 50% Discount.
The main antigen for Plasmodium vivax is the circumsporozoite protein (CSP), which is found on the surface of the sporozoite stage of the parasite. This protein is involved in the initial stages of the parasite's invasion of liver cells after it has been transmitted to a human host through the bite of an infected mosquito. The CSP antigen is a target for the immune system's response to the parasite, and antibodies against CSP can confer some protection against P. vivax infection. Other antigens, such as the merozoite surface protein (MSP), are also important targets for the immune system's response to P. vivax.
The detection of antigens for Plasmodium vivax serves several purposes in the diagnosis, treatment, and prevention of malaria caused by this parasite. Here are some reasons why antigen testing for P. vivax is done:
The sample required for antigen testing for Plasmodium vivax is typically a blood sample.
The test is usually performed on whole blood, which can be collected through a finger prick or venepuncture. In some cases, other bodily fluids such as saliva, urine, or cerebrospinal fluid (CSF) may be used for antigen testing, although blood is the most common and reliable sample type.
It's important to note that the timing of sample collection can affect the accuracy of antigen testing for P. vivax. Antigens are typically detectable in the blood during the early stages of infection when the parasite is actively multiplying in the body. As the infection progresses and the parasite load decreases, antigen levels may become undetectable. Therefore, antigen testing is most reliable when performed early in the course of the disease, before treatment has begun.
The cost of Antigen for plasmodium vivax near me in Delhi ranges from INR to INR
| Test Type | Antigen For Plasmodium Vivax |
| Includes | Antigen For Plasmodium Vivax (Hematology) |
| Preparation | |
| Reporting | Within 24 hours* |
| Test Price |
₹ 350
|

Early check ups are always better than delayed ones. Safety, precaution & care is depicted from the several health checkups. Here, we present simple & comprehensive health packages for any kind of testing to ensure the early prescribed treatment to safeguard your health.